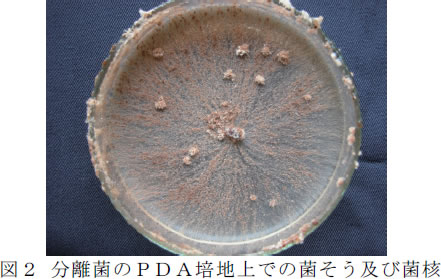

| [成果情報名] | 奈良県内のダリアに発生した‘葉腐れ症状’の病原菌の同定と有効薬剤の検索 |
| [要約] | 近年、県内のダリア産地で問題となっている‘葉腐れ症状’の病原菌はRhizoctonia solani Kuhn AG-1IBであり、病名は葉腐病である。また、本病の防除にはベノミル剤、メプロニル剤、 アゾキシストロビン剤、クレソキシムメチル剤等が有効である。 |
| [キーワード] | ダリア、葉腐病、Rhizoctonia solani、AG-1IB |
| [担当] | 奈良農総セ・研究開発部・環境安全担当・病害防除チーム |
| [連絡先] | 電話0744-22-6201 |
| [区分] | 近畿中国四国農業・生産環境(病害虫) |
| [分類] | 研究・参考 |
[具体的データ]
 |
|


| [その他] | ||
| 研究課題名 | : | 病害虫診断技術調査事業 |
| 予算区分 | : | 国庫(食の安全・安心確保交付金) |
| 研究期間 | : | 2007~2008年度 |
| 研究担当者 | : | 西崎仁博、川上恵理(近畿大学農学部)、百町満朗(岐阜大学応用生物科学部)、平山喜彦、角川由加 |